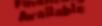
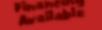

Pg. 17














DINE-IN • TAKE OUT 200 MARKET PLACE CONNECTOR Peachtree City 770-487-9982 Lunch: Mon - Fri 11:00am-3:00pm • Sat & Sun 11:00am-3:00pm Dinner: Sun - Thurs 3:00pm-9:30pm • Fri - Sat 3:00pm-10:00pm ONLINE ORDERING AT GREENGINGERPTC.COM LARGE PRIVATE ROOM (SEATS UP TO 40) LARGE OUTDOOR PATIO Walnut Shrimp Shrimp Lo Mein Godzilla Roll With this coupon. Not Valid with other offers, Lunch Specials, & Course Meals. Limit 1 per table. Expires 4/7/23. 770-487-9982 with purchase of $30 or more Dine-In or Pick-Up FREE Crab Rangoon (6pc) or Tempura Cheesecake (1pc) With this coupon. Excludes Alcohol. Not Valid with other offers, Lunch Specials & Course Meal or Holidays. Limit 1 per table. Expires 4/7/23. 770-487-9982 your purchase of $50 or more DINE-IN ONLY. $10 OFF Lunch Sushi & Sashimi Thai Basil Roll PEACHTREE CITY FULL BAR Seats up to 40 Featuring Chinese, Thai, Japanese & Full Sushi Bar, Upscale Casual Dining Hibachi Steak and Lobster







4 To advertise or to view previous issues, go to our new website at www.TheShopper.net SERVICES OFFERED • Residential • Professional Offices • Small Businesses • Basic Cleaning - Weekly - Bi-Weekly - Monthly • One Time Deep Cleaning Call or Text Norma 678-852-9547 FREE ESTIMATES CLEANING SPECIAL 20% OFF New Clients Only Deep Clean NOT Included




























For information about advertising, call us at 770.954.1983/954.1984 5 FREE (2) CHICKEN EGG ROLLS OR (2) SPRING ROLLS with purchase of $25 or more before tax FREE STEAMED OR PAN FRIED DUMPLING with purchase of $30 or more before tax FREE 4-PC CHICKEN STICKS OR 6-PC CRAB RANGOON with purchase of $30 or more before tax FREE CHICKEN LO MEIN with purchase of $50 or more before tax Please mention Coupon when ordering. Not valid with Family Dinner Specials. Must present coupon. Not Valid with other offers. Expires 4/7/23. FAY CHOPSTICKS • 678-902-1885 Please mention Coupon when ordering. Not valid with Family Dinner Specials. Must present coupon. Not Valid with other offers. Expires 4/7/23. FAY CHOPSTICKS • 678-902-1885 Please mention Coupon when ordering. Not valid with Family Dinner Specials. Must present coupon. Not Valid with other offers. Expires 4/7/23. FAY CHOPSTICKS • 678-902-1885 Please mention Coupon when ordering. Not valid with Family Dinner Specials. Must present coupon. Not Valid with other offers. Expires 4/7/23. FAY CHOPSTICKS • 678-902-1885 Chopsticks Before Af ter 10% OFF any full home duct cleaning O ers cannot be combined. O ers cannot be combined. “Air Duct and Dryer Vent Cleaning” CATESSERVICES . COM Free quotes over the phone! 2022 SERVICING ALL YOUR AIR DUCT AND DRYER VENT NEEDS



























Pressure Washing • Houses Driveways • Pool Decking • Decks • Porches • Fencing • Retaining Walls • Sidewalks ROOF WASHING FREE ESTIMATES BEFORE BEFORE AFTER FLOOR COATING 1080FloorCoating.com Epoxy Garage Floors Concrete Polishing Metallic Floors Concrete Sealing 1080PressureWashing.com 1080FloorCoating.com CALL TODAY 678-849-1600 BEFOREAFTERBEFOREAFTER BEFOREAFTER BEFOREAFTER BEFOREAFTER BEFOREAFTER BEFOREAFTER BEFOREAFTER Not to be combined with any other offers. Any Residential Pressure Washing Not to be combined with any other offers. Roof Washing 10% OFF 10% OFF






















For information about advertising, call us at 770.954.1983/954.1984 7 100 Peachtree East Shopping Center Peachtree City, GA 30269 theitalianoven.com 770.486.9642 Great pizza and pasta dinners at a price you’ll love. A PURCHASE OF 2 LUNCH ENTREES Good toward food and beverage purchases (excluding alcohol). Coupon must be presented at time of order. One coupon per party per visit. Not valid with any other discount o ers. O er expires 4/30/23. FAY Good toward food and beverage purchases (excluding alcohol). Coupon must be presented at time of order. One coupon per party per visit. Not valid with any other discount o ers. O er expires 4/30/23. FAY BUY ONE ENTREE, GET ANOTHER ENTREE OF EQUAL OR LESSER VALUE NOW HIRING ALL POSITIONS Temporary Hours Closed Monday Tues-Fri 11-9pm Saturday 12-9pm Sunday 11-8pm FREE SPRING ROLLS (2) OR CHICKEN EGG ROLLS (2) WITH ORDER OF $20 OR MORE (Excluding tax) With This Coupon. Not Valid With Other Offers. Expires 4/07/23. $5 OFF ANY PURCHASE OF $30 OR MORE (Excluding tax) With This Coupon. Dine In and Pickup. Not Valid With Other Offers. Expires 4/07/23. FREE CRAB RANGOON 6 Pcs. WITH $30 OR MORE (Excluding tax) With This Coupon. Dine In and Pickup. Not Valid With Other Offers. Expires 4/07/23. For Online Orders, Summit Point Center City Hall S Publix Hwy. 85 Hw y. 54 Kroger 840 Glynn Street South, #330 Fayetteville, GA 30214 Summit Point Center (to the left of Publix) www.RoyalChefChinaBistroga.com 770-716-8299 Open Sun., Mon., Wed. & Thurs. 11am - 9:30pm Fri. & Sat 11am - 10pm, Closed Tuesday TAKE-OUT•CATERING WE DELIVER Minimum $20 • Limited Area JOIN US! DINE IN NOW OPEN! Residential & Commercial • References Upon Request Visit Our Website: ShaneSteamers.com 404-468-1401 MASTER TEXTILE CLEANER CALL Family Owned & Operated by Bobby Shane Brooks Certified In: Stone, Masonry, Tile & Grout Cleaning, Carpet Stretching / Repair, Truck Mounted Carpet Cleaning LICENSED & INSURED TheShopper.net TheShopper.net TheShopper.net TheShopper.net With coupon. Not valid with other offers. Expires 4/30/23. With coupon. Not valid with other offers. Expires 4/30/23. With coupon. Not valid with other offers. Expires 4/30/23. With coupon. Not valid with other offers. Expires 4/30/23. 3 ROOMS $15000 $25 FOR EACH ADDITIONAL ROOM COUCH & LOVESEAT STEAMED AND DEODORIZED $17500 TILE & GROUT CLEANING $100 SQ. FT. DEEP CLEAN USING CRB TECHNOLOGY $25 Each Additional Room With coupon. Not valid with other offers. Expires 4/30/23.






8 To advertise or to view previous issues, go to our new website at www.TheShopper.net Yvette D. Best, EA, CTC 4X Best Selling Author 897 Glynn St. N., Fayetteville | info@bsullc.us | www.BestTaxSolutions.us TAX SERVICES • Tax Debt Relief • Audit Representation • Business Returns • Unfiled Returns • Amended Returns BUSINESS ADVISORY • Strategic Planning • Business Plans • Business Funding • Business Credit • Financial Statements IRS Enrolled Agent | Certified Tax Coach 770.461.4829 Admitted to Practice Before the IRS For New Tax Clients. Expires 4/30/23 $50 OFF www.bestfriendsflooring.com HARDWOOD TILE CARPET VINYL/LVT/LVP LAMINATE HARDWOOD TILE CARPET VINYL/LVT/LVP LAMINATE WE OFFER 60% OFF MATERIALS WE REMODEL BATHROOMS AND KITCHENS

For information about advertising, call us at 770.954.1983/954.1984 9 RESIDENTIAL/COMMERCIAL STORMSPECIALISTS • FAMILY OWNED AND OPERATED • 100% SATISFACTION GUARANTEED CREDIT CARDS ACCEPTED FREE ESTIMATES Ask about our militar y, first responder and senior discounts!!!! ASK ABOUT OUR $100 CASH REFERRAL PROGRA M 24 HOUR EMERG E NCYTA R P I N G QUALITY CONCRETE! ★ ★ ★ ★ ★ ★ AFTER BEFORE BEFORE Best Roofer for 2022! ✓ Full Roof Replacement & All Roofing Needs ✓ Gutters/Guards ✓ Gutter Cleaning ✓ Concrete ✓ Fencing ✓ Painting ✓ Metal Structures/Buildings AFTER LICENSED & INSURED OVER 15 YEARS EXPERIENCE! CALL TODAY! 678-521-9747 CALL TODAY! 678-521-9747 Cannot be combined with other offers. Must present coupon at time of estimate. Per insurance paperwork. Expires 4/30/23. TSN A REPAIR JOB OF $250 OR MORE $50 OFF Cannot be combined with other offers. Must present coupon at time of estimate. Per insurance paperwork. Expires 4/30/23. TSN A ROOF JOB OF $7,000 OR MORE $1000 OFF Cannot be combined with other offers. Must present coupon at time of estimate. Per insurance paperwork. Expires 4/30/23. TSN A ROOF JOB OF $6,999 OR LESS $500 OFF
Thank you for coming out and taking care of our septic issue in a timely manner!! Great guys and very polite. I felt like the price was fair and will definitely use them again when needed.











EVERYTHING from installs to repairs to maintenance pumps MILITARY, EDUCATOR, SENIOR & FIRST RESPONDER DISCOUNTS Family Owned & Operated (706) 590-8426 www.bigdaddysseptic.com 24 Hour Emergency Service FREE ESTIMATES PROVIDING SERVICES SUCH AS: - Drain Cleaning - Camera Inspections - Sewage Pumps - Baffle Tee Repairs - Inspection Letters - Hydro Jetting - Main Lines - Clean Out Install - Field Lines - Risers and more! Trace is AMAZING. 10/10 recommend. He was so patient with my family and truly looked out for us during our entire experience. He was able to find the issue and repair within 24 hours.... A. JONES Big Daddy’s Septic went above what was expected to be done. I would highly recommend them to
I can.
found
the problem was and
customer service. GAROB
K. PENDERGRASS 5% off Septic Repairs With this coupon. Cannot be combined with other coupons. Offer expires 4/30/23. March Special
everyone
They
what
spent the time to fix it. Great
770.468.0014

MONDAY - FRIDAY 8:00AM-5:00PM
Roof Cleaning
House Washing

Soft Washing
Pressure Washing

Concrete Cleaning

MENTION THIS AD AND RECEIVE
10% off
Offer expires 4/30/23.
Commercial Window Cleaning
Christmas Light Installation
“Firehouse is the most experienced exterior cleaning service in the area. We have been soft washing, pressure washing and roof cleaning since 1998 and have formed an incredible team of ALL Firefighters to take care of any exterior cleaning needs you may have. Concrete pressure washing, roof cleaning, soft washing and gutter cleaning can all be performed by off duty Firefighters who are trained on building construction and safety and who are guardians of the community. Operating with the highest of morals and ethics is The Firehouse Standard. And remember, “No one is better with water than a Firefighter on their day off”
Commercial Structure and Concrete Cleaning
: www.firehousepowerwash.com


: https://www.facebook.com/firehousepowerwash : @firehousepowerwash



: firefighterswashinghomes










o advertise or to view previous issues, go to our new website at www.TheShopper.net Book your Pamper Party at BRC Medhealth Call or book online 470.301.4563 | www.brcmedhealth.com BRC MEDHEALTH MINI CLINIC AND AESTHETICS STUDIO 110 North Park Dr., Fayetteville, Ga 30214 | 470.301.4563 Up to 6 guests or book an individual pamper session! Self Care Designed with you in Mind! @BRCmedhealth! #beautyisourduty! Check out our website for packages under the special offers tab for rates on group and individual packages. Sunday Pamper parties are available for an additional service fee. Light Cuisine and Refreshments are included with packages. Book yours today!





You Asked, We Answered Low-Cost Pools That Fit Your Budget and Backyard! "J-Series" Freeform Sizes "M-Series" Geometric Sizes Discounted Prices Starting At $48,000 Financing Available Call Now (770) 430-4663 Offers Valid Through March 15 Scan To See Pricing!�










For information about advertising, call us at 770.954.1983/954.1984 15 TRUST THE TEAM WITH EXPERIENCE SERVING THE ATLANTA, GA AREA • FULLY INSURED • OVER 15 YEARS EXPERIENCE 770.203.7714 MeridianTreeServiceAtl.com COUPON REQUIRED 25% OFF ANY ESTIMATE OF $1000 OR MORE! Must present coupon when scheduling appointment. One discount per household. Cannot be combined with any other specials or offers. Excludes prior services. Expires 4/30/23 FAMILY OWNED AND OPERATED 678-544-9267 FREE GUTTER GUARDS WITH ROOF AND GUTTER PURCHASE Fully Insured Family Owned and Operated FREE ESTIMATES | Located on: $500 OFF ROOF REPLACEMENT $6,000 OR MORE 10% OFF ROOF REPAIRS Offer expires 4/30/23. Offer expires 4/30/23. Specializing in New Roofing, Leak Repairs, Emergency Repairs, Gutters & more! PITCHPERFECTRG.COM Financing Available!












RESIDENTIAL & COMMERCIAL • Licensed & Insured CALL LAWRENCE POPE 678-628-6153 FOR FREE ESTIMATES CONCRETE DRIVEWAYS SIDEWALKS • PATIOS GRADING • STAMPING • ACID STAIN SAMUEL BROWNLEE - 678-544-9832 or email: brownlee.samuel@yahoo.com CALL FOR FREE ESTIMATE! WHY PAY MORE? when you get better for less OVER 30 YEARS EXPERIENCE in concrete work ONE STOP Resource FOR ALL YOUR CONCRETE WORK PRIME DESIGN CoNCREtE FINIShING








We have the tools and the time to handle those projects you’ve No job is too big or too small. Frameless Glass Shower Doors Also Decks • Wood Floors • Tile Floors 4 Plumbing 4 Electrical 4 Roofing 4 Tile Deluxe Model ELLA WALK-IN TUBS OFFERS INDEPENDENCE SO THAT YOU CAN STAY IN YOUR HOME WITH COMFORT AND CONFIDENCE, WITH MORE FEATURES AND LESS COST THAN ANY OTHER WALK-IN TUB. Why Pay More... when you can get better for less! MAKING YOUR DREAMS A REALITY Providing such products as: Cambria Quartz • Artisan Granite Saratoga Soapstone • Heritage Wood • Natural Stone Granite, Marble, Travertine • Quartz Call Us Today 678-628-6153






























18 To advertise or to view previous issues, go to our new website at www.TheShopper.net We’re More Than Just A Magazine! At TheShopper.net, we offer a full-range of printing, graphic and mailing services in addition to advertising opportunities in our monthly/bi-monthly magazines! PAID MCDONOUGH, RESIDENTIAL CUSTOMER The Best Roofing Company Newnan, GA Offers insured Free Consultations Free (678) 782-3852 TODAY FOR ALL YOUR ROOFING NEEDS! Tru-Top Roofing is your one-call provider for complete residential and commercial roofing, gutters, siding, and windows. Whether you need a new roof installation or repairs, trust our skilled and experienced professionals to help you. • Residential Roofing • Commercial Roofing • Gutter Installation • Siding Installation • Deck Construction • Windows OUR SERVICES: DAMAGED ROOFING, SIDING OR GUTTERS? CALL NOW FOR A FREE INSPECTION! (678) 782-3852 PROTECT YOUR HOME TODAY! WE OFFER 24 HOUR EMERGENCY SERVICE Call today or visit us at www.TruTopRoofing.com Locally Known, Veteran Owned & Trusted In a world full of patients, we only see you. Because our most important patient is you. PAID MCDONOUGH, Careat Jackson, PAID MilamTreeServices.com 2216 Hwy 81 East McDonough, GA 30252 Customer Name Phone Email Billing Location Billing Location Job Location (if different) Description Cut Stumps Low Grind Stumps Leave Stump Chips Payment is due at time Remove Stump Chips MilamTreeServices.com 2216 Hwy 81 East McDonough, GA 30252 Customer Name Phone Billing Location Billing Location Job Location (if different) o o o o o EITHER CREW Description Stumps Low Complete Clean Up: YES NOJob Completed to www.milamtreeservices.com 770-914-7776 770-914-7776 The Walter and Emilie Spivey Foundation and Clayton State University present LEIF OVE ANDSNES SATURDAY, JANUARY 28, 2023 3:00PM 2022-2023 SPIVEY HALL CONCERT SEASON IS SPONSORED BY The Walter and Emilie Spivey Foundation Barney M. Franklin and Hugh W. Burke Charitable Fund Richard Owens Charitable Foundation Spivey Hall Education and Community Sponsor: Richard F. Tigner 2074 JODECO MCDONOUGH, OFFICE: 678-812-1427 1701 42 N MCDONOUGH, 30253 OFFICE: 678-814-4781 LET’S VAPE LLC Customer 15% OFF ALL CBD PRODUCTS 15% OFF CBD PRODUCTS 2074 JODECO ROAD MCDONOUGH, GA OFFICE 678-812-1427 1701 HWY. MCDONOUGH, OFFICE 678-814-4781 CELL 678-814-7176 AND $5 OFF ANY PURCHASE OF $20 OR 15% OFF ANY E-LIQUIDS With BUY 2 VAPES GET ONE FREE coupon.offers. 15% OFF CBD FLOWER Cannot $20 OFF PURCHASE OF $100 OR MORE Cannot $5 OFF ANY MODS Cannot BUY 2, GET ONE FREE HOOKAH FLAVORS $10 OFF GLASS BONGS 770-954-1983 or 770-954-1984 Services@TheShopper.net www.TheShopper.net @TheShopper_magazine TheShopper.Net Come Grow With Us! $.16 POSTCARDS AS LOW AS Includes Design, Printing & Postage. Runs with magazine distribution. No minimums. LETTER SHOP SERVICES MAILING SERVICES GRAPHIC SERVICES PRINTING SERVICES • INKJET ADDRESSING • MAIL MERGE SERVICES • VARIABLE TEXT PRINTING • FOLDING • INSERTING • TABBING • LABELING • LIVE STAMPING • METERING • PRESORTING • DIRECT MAIL • STANDARD MAIL • 1st CLASS PRESORT MAIL • POLITICAL MAIL • PERIODICAL MAIL • FUND RAISING LETTERS • GRAPHIC DESIGN • ARTWORK CREATION • BROCHURES • POSTCARDS • SELF-MAILERS • NEWSLETTERS • MAGAZINES • CATALOGS • LETTERHEAD/ENVELOPES










Elegant Frameless Shower Enclosures & Frameless Sliding Shower Doors Beautiful Wine Cellar & Glass Wall Doors Glass Handrails ....Over 15 Years of Experience WE ARE THE BEST!!! Serving Fayette, Coweta & Surrounding Areas! 404-849-0003 Come See Our Showroom! 190 Promenade Pkwy., Fayetteville, Ga. 30214 SBGlass.com Making Your Glass Dreams Come True!








upfence@gmail.com • upchurchfence.com FREE Estimates 770 -775 - 4397 Established 1997 Services • Fence Installation and Material Sale • Estate Gates and Operator Systems • Commercial and Residential • Temporary Fence Panels • Wood Fence Restoration and Staining • Decking • Brick and Stone Work • Concrete Work • Powder Coating • Surveying • Machine Rental • Machine with Operator for Hire Wheat Straw and Pine Straw For Sale Mon-Fri 8AM-5PM • Sat 9AM-2PM Hours: CUSTOMER SATISFACTION COMES FIRST! Mention This Ad at Time of Estimate AND RECEIVE A DISCOUNT! ALL WORK FULLY GUARANTEED! Licensed - Bonded - Insured Layaway and Gift Certificates Available for the BGE! NOWHIRING... EXPERIENCEDFENCECREWSANDHELPERS


www.ventureroofingllc.com 251 Tiger Way Peachtree City, GA 30269 678-656-7482

We Now Have A “Turf Friendly” 90 Ft. Lift! • Fully Licensed & Insured With Workers’ Compensation • State-of-the Art Equipment • 24-Hour Service • 20 Years Experience • Turf Friendly Equipment • Experts in Hazardous Tree Removal • Residential & Commercial • Free Estimates • Free Estimates We are the solution for all your tree care needs! 971 Hwy. 155N • McDonough, GA Owner Operator Tim Malin Direct Line: (678) 432-3332 Emergency Calls: (678) 758-4624 | McDonough, GA GA


























































































































24 To advertise or to view previous issues, go to our new website at www.TheShopper.net Commercial / Residential We will beat any competitors pricing by 10% GUARANTEED • FREE STUMP GRINDING with every tree • Forestry Mulching 678-282-7164 FREE ESTIMATES Licensed & Insured Best Price Tree Removal Licensed & Insured Senior Citizen Discounts References Available Upon Request SERVICES INCLUDE: • KITCHENS & BATHS • SIDING • FLOORING • DECKS (From basic to not-so-basic) • PORCHES • COVERED PORCHES • PATIOS • ELECTRICAL • PLUMBING AND MORE! FROM CONCEPT TO CREATION Let your dreams be our project. NOAH DIXON 470.687.8576 noahgrayson73@icloud.com DIXON HOME RENOVATIONS HAPPY




For information about advertising, call us at 770.954.1983/954.1984 25 SPECIAL OFFER ON QUARTZ COUNTERTOPS! Installed from $45 Sq/Ft. Minimum 40 Sq/Ft. 164 Weldon Rd., Palmetto,GA (exit 56 off I-85) AmazonStone.com 770-251-8299 770-251-8299 SCHEDULE YOUR Consultation! FREE KITCHENS & BATH S WH ERE COME TO LI FE! Limite dTimeOffe r REFERRAL FEE PROGRAM* *Call for Details Bathrooms Made Easy! From $12,995* • Granite • Marble • Soapstone • Quartz • Sinks • Faucets • Cabinets • Hardware • Tile • Engineered Hardwood • LVP & LVT Best Selection Under One Roof! Granite n Tiles n Cabinets n Flooring & More WE DO IT ALL! KITCHENS & BATHS Showroom Mon-Fri 9:00am - 5:00pm • Sat 10:00am - 3:00pm













26 To advertise or to view previous issues, go to our new website at www.TheShopper.net CALL NOW! 678-788-0050 A DIVISION OF TITAN BUILD GROUP HENRY COUNTY’S HIGHEST AWARDED CONSTRUCTION GROUP FOR • ROOFING • WINDOWS • DECKS * Cleaning/Safety Inspections * Gas Logs * Fire Tables * Fire Pits * Repair/Replacement of Gas Fireplaces * Chimney Caps * Leak Repair * Much More WES MOONEY Senior Project Manager/Titan Build Group Co-Founder/ATLChimney.com | NFI Technician ATLCHIMNEY.COM Atlchimney@gmail.com $169 Cannot be combined with other offers. Offer expires 4/30/23. Cleaning & Inspection • Yearly Lawn Maintenance Packages Available • Artificial Turf Installation • Landscape Design and Installation • Landscape Lighting • Retaining Walls • Pavers • Fire pits Brooks Landscaping provides maintenance to commercial properties as well as HOAs. Our team of professionals is backed by years of experience to make that dream of a perfect, manicured landscape a reality. Each client’s needs are met through continuous communication and regular site inspections. ARE YOU LOOKING TO BEAUTIFY YOUR HOA OR BUSINESS? Before After Before After



We are Hiring Plumbers!








30 To advertise or to view previous issues, go to our new website at www.TheShopper.net 0% FINANCING FOR 60 MONTHS ON QUALIFYING SYSTEMS! Free Service Call With Repair for Seniors (60 and older), Military, Teachers and First Responders $500 VISA CARD MANUFACTURERS REBATE* *ON SELECT SYSTEMS FREE FREON WITH REPAIRS “We are praying for all families affected by Cov-19” OMEGA HEATING & AIR 404-438-0353 Must present coupon when receiving estimate. Cannot be combined with other coupons. Offer expires 4/30/23. $69.95 AIR-CONDITION TUNE UP WITH FREE 1” PLEADED AIR-FILTER FREE WARRANTY 90 DAY WARRANTY & FREE DIAGNOSTIC CALL AFTER TUNE-UP 2 TON AIR-CONDITION UNIT WITH MATCHING COIL AND FURNACE OMEGA HEATING & AIR 404-438-0353 Must present coupon when receiving estimate. Cannot be combined with other coupons. Offer expires 4/30/23. RECEIVE UP TO A $500.00 REBAT E ON ENERGY STAR RATED FURNACE OMEGA HEATING & AIR 404-438-0353 Must present coupon when receiving estimate. Cannot be combined with other coupons. Offer expires 4/30/23. OMEGA HEATING & AIR 404-438-0353 Must present coupon when receiving estimate. Cannot be combined with other coupons. Offer expires 4/30/23. WANT PEACE OF MIND: 10 YEAR PARTS WARRANTY, 5 YEAR LABOR WARRANTY, LIFETIME WARRANTY ON ANY NEW UNIT. 10% DISCOUNT FOR ALL REPAIR WORK $139.00PER MONTH $99.00PER MONTH WITH PURCHASE OF HIGH EFFICIENCY AIR-CONDITION UNIT FREE FURNACE STARTING AT STARTING AT *System maintenance required. March 2023 Only. Call for Details. OMEGA HEATING & AIR • 404-438-0353 1035 South Hill Street • Griffin, GA 30224 (770) 228-7759 Flight Training Aircraft Rental Flight Reviews Financing Available Gift Certificates www.flyboys.biz First Flight Lesson $297 including 1 hour of ground and 1 hour of flight.

Before After Before After Before After $50.00 With Any Repair NYLON ROLLER UPGRADE Cannot be combined with any other offers. Expires 4/30/23. $50.00 OFF ANY LIFTMASTER MOTOR Cannot be combined with any other offers. Expires 4/30/23. $200.00 OFF Any Double Wide Door Replacement Cannot be combined with any other offers. Expires 4/30/23. $50 OFF SPRING REPLACEMENT Cannot be combined with any other offers. Expires 4/30/23. Cannot be combined with any other offers. Expires 4/30/23.















PRESORT STANDARD ECRWSS U.S. POSTAGE PAID McDonough, GA Permit No. 30 POSTAL CUSTOMER Page 2 Page 5 Page 7 Page 7 Page 10 Page 11 Page 13 Page 14 Page 19 Page 20


























































































































































































































































































































